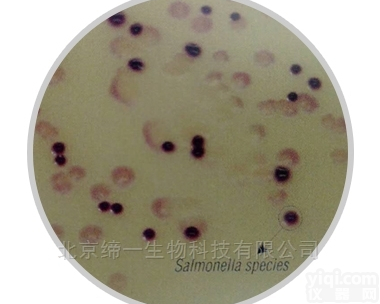
M1842  <em>沙门氏菌选择性显色培养基</em>

沙门氏菌选择性显色培养基
- 型号:M1842
- 产地:中国大陆
- 供应商:上海威正翔禹生物科技有限公司
- 供应商报价:电议
- 标签:沙门氏菌选择性显色培养基,生命科学,细胞分析,供应沙门氏菌选择性显色培养基,上海威正翔禹生物科技有限公司
HiCrome Selective Salmonella Agar Base
用途
从食品中选择性分离和鉴别沙门氏菌
原理
显色原区分肠杆菌科和沙门氏菌
克雷伯菌和肠杆菌-蓝至深蓝色克隆
沙门氏菌-粉色克隆
其他肠杆菌科-无色
胆酸钠、牛磺胆酸钠和脱氧胆酸内增加选择性—革兰氏阳性菌被YZ
| 货号/规格 | 产品名称 | 价格 |
| M1842-100G | HiCrome Selective Salmonella Agar Base | 询价 |
| M1842-500G | HiCrome Selective Salmonella Agar Base | 询价 |